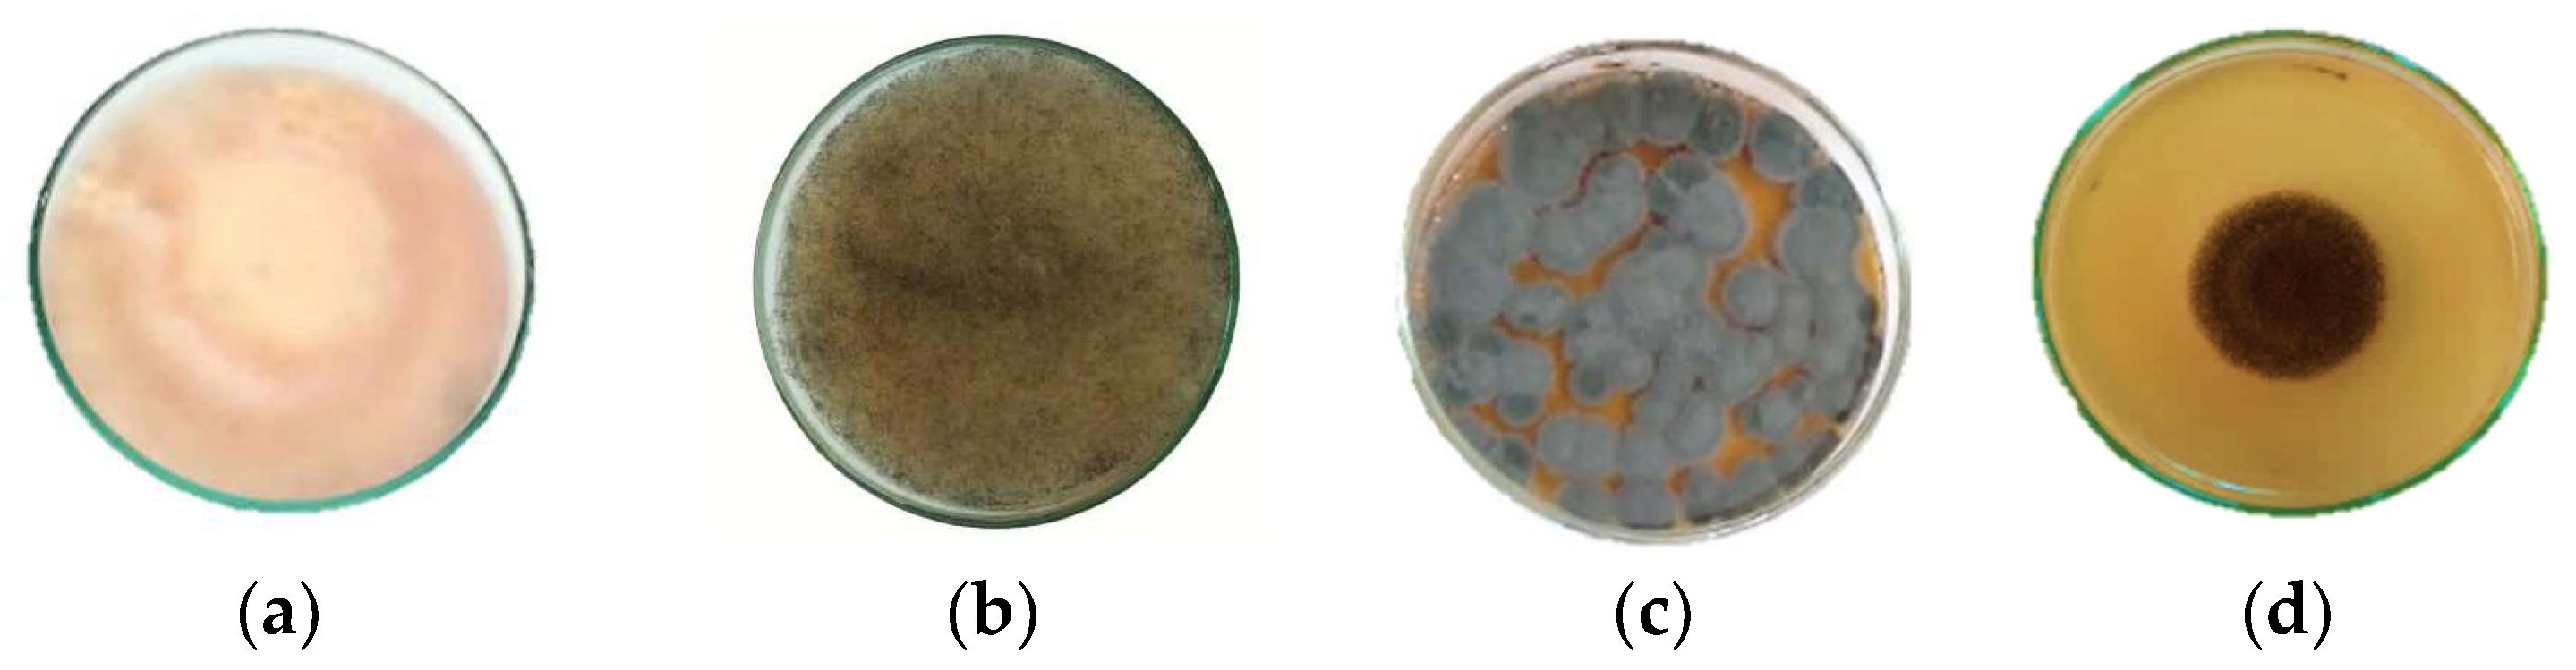
Plants 12 03587 g002

In Vitro Antioxidant and Antifungal Activities of Four Essential Oils and Their Major Compounds against Post-Harvest Fungi Associated with Chickpea in Storage
Abstract
:1. Introduction
2. Results
2.1. Essential Oil Yields
2.2. Chemical Composition of Essential Oils
2.3. Antioxidant Activity of Essential Oils
2.4. Antifungal Activity
2.4.1. Antifungal Activity of Essential Oils
2.4.2. Antifungal Activity of the Main Components of EOs
2.4.3. Antifungal Activity of the Main Component Mixture
2.5. Correlation Analysis between Antifungal and Antioxidant Activities
3. Discussion
4. Materials and Methods
4.1. Plant Materials and Extraction of Essential Oils
4.2. Gas Chromatography–Mass Spectrometry Analysis of Essential Oil
4.3. Major Components of the EOs
4.4. Antioxidant Activity
4.4.1. DPPH Radical Scavenging Activity
4.4.2. ABTS Anion Radical Scavenging Activity
4.4.3. Total Antioxidant Capacity
4.5. Antifungal Activity
4.5.1. Fungal Isolates and Inoculum Preparation
4.5.2. Determination of the Minimum Inhibitory Concentration (MIC)
4.5.3. Determination of the Minimum Fungicidal Concentration (MFC)
4.5.4. Determination of the Fractional Inhibitory Concentration Index (FICI)
4.6. Statistical Analysis
5. Conclusions
Author Contributions
Funding
Acknowledgments
Conflicts of Interest
References
- Ingram, J. A food systems approach to researching food security and its interactions with global environmental change. Food Sec. 2011, 3, 417–431. [Google Scholar] [CrossRef]
- Mc Carthy, U.; Uysal, I.; Badia-Melis, R.; Mercierb, S.; O’Donnelld, C.; Ktenioudakid, A. Global food security—Issues, challenges and technological solutions. Trends Food Sci. Technol. 2018, 77, 11–20. [Google Scholar] [CrossRef]
- Waszkowiak, K.; Szymandera-Buszka, K.; Hęś, M. Effect of ethanolic fl ax (Linum usitatissimum L.) extracts on lipid oxidation and changes in nutritive value of frozen-stored meat products. Acta Sci. Pol. Technol. Aliment. 2014, 13, 135–144. [Google Scholar] [CrossRef] [PubMed]
- Huang, L.; Xiong, Y.L.; Kong, B.; Huang, X.; Li, J. Influence of storage temperature and duration on lipid and protein oxidation and flavour changes in frozen pork dumpling filler. Meat Sci. 2013, 95, 295–301. [Google Scholar] [CrossRef] [PubMed]
- Barbhuiya, R.I.; Singha, P.; Singh, S.K. A comprehensive review on impact of non-thermal processing on the structural changes of food components. Food Res. Int. 2021, 149, 110647. [Google Scholar] [CrossRef]
- Rasooli, I. Food Preservation—A Biopreservative Approach. Food 2007, 1, 111–136. [Google Scholar]
- Mannaa, M.; Deok Kim, K. Influence of Temperature and Water Activity on Deleterious Fungi and Mycotoxin Production during Grain Storage. Mycobiology 2017, 45, 240–254. [Google Scholar] [CrossRef]
- Manzur, M.; Luciardi, M.C.; Blázquez, M.A.; Alberto, M.R.; Cartagena, E.; Arena, M.E. Citrus sinensis Essential Oils an Innovative Antioxidant and Antipathogenic Dual Strategy in Food Preservation against Spoliage Bacteria. Antioxidants 2023, 12, 246. [Google Scholar] [CrossRef] [PubMed]
- Nieto, G.; Jongberg, S.; Andersen, M.L.; Skibsted, L.H. Thiol oxidation and protein cross-link formation during chill storage of pork patties added essential oil of oregano, rosemary, or garlic. Meat Sci. 2013, 95, 177–184. [Google Scholar] [CrossRef] [PubMed]
- Ghamdi, F.L.A.; Bokhari, F.M.; Aly, M.M. Toxigenic fungi associated with dried Fruits and fruit-based products collected from Jeddah province. IOSR-JPBS 2019, 14, 10–20. [Google Scholar] [CrossRef]
- Bakkali, F.; Averbeck, S.; Averbeck, D.; Idaomar, M. Biological effects of essential oils—A review. Food Chem. Toxicol. 2008, 46, 446–475. [Google Scholar] [CrossRef] [PubMed]
- Karadayı, M.; Yıldırım, V.; Güllüce, M. Antimicrobial Activity and Other Biological Properties of Oregano Essential Oil and Carvacrol. Anatol. J. Biol. 2020, 17, 52–68. [Google Scholar]
- Ramzi, A.; Lalami, A.E.; Ez zoubi, Y.; Assouguem, A.; Almeer, R.; Najda, A.; Ullah, R.; Ercisli, S.; Farah, A. Insecticidal Effect of Wild-Grown Mentha pulegium and Rosmarinus officinalis Essential Oils and Their Main Monoterpenes against Culex pipiens (Diptera: Culicidae). Plants 2022, 11, 1193. [Google Scholar] [CrossRef] [PubMed]
- Kiki, M.J. In Vitro Antiviral Potential, Antioxidant, and Chemical Composition of Clove (Syzygium aromaticum) Essential Oil. Molecules 2023, 28, 2421. [Google Scholar] [CrossRef] [PubMed]
- Barbosa, C.H.; Andrade, M.A.; Vilarinho, F.; Castanheira, I.; Fernando, A.L.; Loizzo, M.R.; Sanches Silva, A. A New Insight on Cardoon: Exploring New Uses besides Cheese Making with a View to Zero Waste. Foods 2020, 9, 564. [Google Scholar] [CrossRef] [PubMed]
- Do Nascimento, L.D.; Barbosa de Moraes, A.A.; da Costa, K.S.; Pereira Galúcio, J.M.; Taube, P.S.; Leal Costa, C.M.; Cruz, J.N.; de Aguiar Andrade, E.H.; Guerreiro de Faria, L.J. Bioactive Natural Compounds and Antioxidant Activity of Essential Oils from Spice Plants: New Findings and Potential Applications. Biomolecules 2020, 10, 988. [Google Scholar] [CrossRef] [PubMed]
- Sarkic, A.; Stappen, I. Essential Oils and Their Single Compounds in Cosmetics—A Critical Review. Cosmetics 2018, 5, 11. [Google Scholar] [CrossRef]
- Almeida, L.Q.; Do Nascimento, L.D.; Da Costa, F.A.M.; da Costa, K.S.; de Aguiar Andrade, E.H. In Vitro Antibacterial Activity and in Silico Analysis of the Bioactivity of Major Compounds Obtained from the Essential Oil of Virola surinamensis Warb (Myristicaceae). J. Food Qual. 2022, 2022, 5275805. [Google Scholar] [CrossRef]
- Khorshidian, N.; Yousefi, M.; Khanniri, E.; Mortazavian, A.M. Potential application of essential oils as antimicrobial preservatives in cheese. Innov. Food Sci. Emerg. Technol. 2017, 45, 62–72. [Google Scholar] [CrossRef]
- Cherrat, L.; Espina, L.; Bakkali, M.; García-Gonzalo, D.; Pagán, R.; Laglaoui, A. Chemical composition and antioxidant properties of Laurus nobilis L. and Myrtus communis L. essential oils from Morocco and evaluation of their antimicrobial activity acting alone or in combined processes for food preservation. J. Sci. Food Agric. 2013, 94, 1197–1204. [Google Scholar] [CrossRef]
- Barberis, S.; Quiroga, H.G.; Barcia, C.; Talia, J.M.; Debattista, N. Natural Food Preservatives Against Microorganisms. In Food Safety and Preservation; Elsevier: Amsterdam, The Netherlands, 2018; pp. 621–658. [Google Scholar] [CrossRef]
- Ogunnupebi, T.A.; Oluyori, A.P.; Dada, A.O.; Oladeji, O.S.; Inyinbor, A.A.; Egharevba, G.O. Promising Natural Products in Crop Protection and Food Preservation: Basis, Advances, and Future Prospects. Int. J. Agron. 2020, 2020, 8840046. [Google Scholar] [CrossRef]
- Du, W.X.; Avena-Bustillos, R.J.; Hua, S.S.T.; McHugh, T.H. Antimicrobial volatile essential oils in edible films for food safety. In Science against Microbial Pathogens: Communicating Current Research and Technological Advances; Formatex Research Center: Badajoz, Spain, 2011; Volume 2, pp. 1124–1134. [Google Scholar]
- Angane, M.; Swift, S.; Huang, K.; Butts, C.A.; Quek, S.Y. Essential Oils and Their Major Components: An Updated Review on Antimicrobial Activities, Mechanism of Action and Their Potential Application in the Food Industry. Foods 2022, 11, 464. [Google Scholar] [CrossRef] [PubMed]
- Lucera, A.; Costa, C.; Conte, A.; Del Nobile, M.A. Food applications of natural antimicrobial compounds. Front Microbiol. 2012, 3, 287. [Google Scholar] [CrossRef] [PubMed]
- Ghavam, M. Relationships of irrigation water and soil physical and chemical characteristics with yield, chemical composition and antimicrobial activity of Damask rose essential oil. PLoS ONE 2021, 16, e0249363. [Google Scholar] [CrossRef]
- Dhifi, W.; Bellili, S.; Jazi, S.; Bahloul, N.; Mnif, W. Essential Oils’ Chemical Characterization and Investigation of Some Biological Activities: A Critical Review. Medicines 2016, 3, 25. [Google Scholar] [CrossRef]
- Saptarini, N.M.; Wardati, Y. Effect of Extraction Methods on Antioxidant Activity of Papery Skin Extracts and Fractions of Maja Cipanas Onion (Allium cepa L. var. ascalonicum). Sci. World J. 2020, 6, 3280534. [Google Scholar] [CrossRef]
- Abdelmoety, A.A.; Foda, F.F.A.; El-Hadary, A.E.; Abo-El-Seoud, M.A. Impact of Γ-Irradiation on Chemical Constituents, Antibacterial and Antioxidant Activity of Clove and Cinnamon Volatile Oils. J. Chem. Technol. Biotechnol. 2023, 14, 35–41. [Google Scholar] [CrossRef]
- Hadidi, M.; Pouramin, S.; Adinepour, F.; Haghani, S.; Jafari, S.M. Chitosan nanoparticles loaded with clove essential oil: Characterization, antioxidant and antibacterial activities. Carbohydr. Polym. 2020, 236, 116075. [Google Scholar] [CrossRef]
- Dashipour, A.; Khaksar, R.; Hosseini, H.; Shojaee-Aliabadi, S.; Ghanati, K. Physical, Antioxidant and Antimicrobial Characteristics of Carboxymethyl Cellulose Edible Film Cooperated with Clove Essential Oil. Zahedan J. Res. Med. Sci. 2014, 16, 34–42. [Google Scholar]
- Zengin, H.; Baysal, A.H. Antioxidant and Antimicrobial Activities of Thyme and Clove Essential Oils and Application in Minced Beef: Essential Oils and Application in Meat. J. Food Process. Preserv. 2014, 39, 1261–1271. [Google Scholar] [CrossRef]
- Guenane, H.; Gherib, A.; Carbonell-Barrachina, Á.; Cano-Lamadrid, M.; Krika, F.; Berrabah, M.; Maatallah, M.; Bakchiche, B. Minerals analysis, antioxidant and chemical composition of extracts of Laurus nobilis from southern Algeria. J. Mater. Environ. Sci. 2016, 7, 4253–4261. [Google Scholar]
- Das, M.; Roy, S.; Guha, C.; Saha, A.K.; Singh, M. In vitro evaluation of antioxidant and antibacterial properties of supercritical CO2 extracted essential oil from clove bud (Syzygium aromaticum). J. Plant Biochem. Biotechnol. 2020, 30, 387–391. [Google Scholar] [CrossRef]
- Kabuto, H.; Tada, M.; Kohno, M. Eugenol [2-Methoxy-4-(2-propenyl)phenol] Prevents 6-Hydroxydopamine-Induced Dopamine Depression and Lipid Peroxidation Inductivity in Mouse Striatum. Biol. Pharm. Bull. 2007, 30, 423–427. [Google Scholar] [CrossRef] [PubMed]
- Gülçin, İ. Antioxidant Activity of Eugenol: A Structure–Activity Relationship Study. J. Med. Food 2011, 14, 975–985. [Google Scholar] [CrossRef]
- Ulanowska, M.; Olas, B. Biological Properties and Prospects for the Application of Eugenol—A Review. Int. J. Mol. Sci. 2021, 22, 3671. [Google Scholar] [CrossRef]
- Jirovetz, L.; Buchbauer, G.; Stoilova, I.; Stoyanova, A.; Krastanov, A.; Schmidt, E. Chemical Composition and Antioxidant Properties of Clove Leaf Essential Oil. J. Agric. Food Chem. 2006, 54, 6303–6307. [Google Scholar] [CrossRef]
- Dahham, S.S.; Tabana, Y.M.; Iqbal, M.A.; Ahamed, M.B.K.; Ezzat, M.O.; Majid, A.S.A.; Majid, A.M.S.A. The Anticancer, Antioxidant and Antimicrobial Properties of the Sesquiterpene β-Caryophyllene from the Essential Oil of Aquilaria crassna. Molecules 2015, 20, 11808–11829. [Google Scholar] [CrossRef]
- Vanin, A.B.; Orlando, T.; Piazza, S.P.; Puton, B.M.S.; Cansian, R.L.; Oliveira, D.; Paroul, N. Antimicrobial and Antioxidant Activities of Clove Essential Oil and Eugenyl Acetate Produced by Enzymatic Esterification. Appl. Biochem. Biotechnol. 2014, 174, 1286–1298. [Google Scholar] [CrossRef]
- Kulisic, T.; Radonic, A.; Milos, M. Inhibition of lard oxidation by fractions of different essential oils. Grasas Y Aceites 2005, 56, 284–291. [Google Scholar] [CrossRef]
- Sharifi-Rad, M.; Varoni, M.E.; Iriti, M.; Martorell, M.; Setzer, W.N.; Contreras, M.D.M.; Salehi, B.; Soltani-Nejad, A.; Rajabi, S.; Tajbakhsh, M.; et al. Carvacrol and human health: A comprehensive review: Carvacrol and Human Health. Phytother. Res. 2018, 32, 1675–1687. [Google Scholar] [CrossRef]
- Carvalho, F.O.; Silva, É.R.; Gomes, I.A.; Santana, H.S.R.; Santos, D.N.; Souza, G.P.O.; Silva, D.J.; Monteiro, J.C.M.; Júnior, R.L.C.A.; Araújo, A.A.S.; et al. Anti-inflammatory and antioxidant activity of carvacrol in the respiratory system: A systematic review and meta-analysis. Phytother. Res. 2020, 34, 2214–2229. [Google Scholar] [CrossRef] [PubMed]
- Özkan, A.; Erdoğan, A. A comparative evaluation of antioxidant and anticancer activity of essential oil from Origanum onites (Lamiaceae) and its two major phenolic components. Turk. J. Biol. 2011, 35, 735–742. [Google Scholar] [CrossRef]
- Wang, W.; Wu, N.; Zu, Y.G.; Fu, Y.J. Antioxidative activity of Rosmarinus officinalis L. essential oil compared to its main components. Food Chem. 2008, 108, 1019–1022. [Google Scholar] [CrossRef]
- Chrysargyris, A.; Mikallou, M.; Petropoulos, S.; Tzortzakis, N. Profiling of Essential Oils Components and Polyphenols for Their Antioxidant Activity of Medicinal and Aromatic Plants Grown in Different Environmental Conditions. Agronomy 2020, 10, 727. [Google Scholar] [CrossRef]
- Asem, N.; Abdul Gapar, N.A.; Abd Hapit, N.H.; Omar, E.A. Correlation between total phenolic and flavonoid contents with antioxidant activity of Malaysian stingless bee propolis extract. J. Apic. Res. 2019, 59, 437–442. [Google Scholar] [CrossRef]
- Noshad, M.; Behbahani, B.A.; Jooyandeh, H.; Rahmati-Joneidabad, M.; Kaykha, M.E.H.; Sheikhjan, M.G. Utilization of Plantago major seed mucilage containing Citrus limon essential oil as an edible coating to improve shelf-life of buffalo meat under refrigeration conditions. Food Sci. Nutr. 2021, 9, 1625–1639. [Google Scholar] [CrossRef]
- Biernasiuk, A.; Baj, T.; Malm, A. Clove Essential Oil and Its Main Constituent, Eugenol, as Potential Natural Antifungals against Candida spp. Alone or in Combination with Other Antimycotics Due to Synergistic Interactions. Molecules 2022, 28, 215. [Google Scholar] [CrossRef]
- Chen, C.; Cai, N.; Chen, J.; Wan, C. Clove Essential Oil as an Alternative Approach to Control Postharvest Blue Mold Caused by Penicillium italicum in Citrus Fruit. Biomolecules 2019, 9, 197. [Google Scholar] [CrossRef] [PubMed]
- Ennouri, A.; Lamiri, A.; Essahli, M.; Bencheqroun, S.K. Chemical Composition of Essential Oils and Their Antifungal Activity in Controlling Ascochyta rabiei. J. Agr. Sci. Technol. 2020, 22, 1371–1381. [Google Scholar]
- Nazzaro, F.; Fratianni, F.; Coppola, R.; Feo, V.D. Essential Oils and Antifungal Activity. Pharmaceuticals 2017, 10, 86. [Google Scholar] [CrossRef]
- Bedoya-Serna, C.M.; Dacanal, G.C.; Fernandes, A.M.; Pinho, S.C. Antifungal activity of nanoemulsions encapsulating oregano (Origanum vulgare) essential oil: In vitro study and application in Minas Padrão cheese. Braz. J. Microbiol. 2018, 49, 929–935. [Google Scholar] [CrossRef] [PubMed]
- Schmidt, E.; Jirovetz, L.; Wlcek, K.; Buchbauer, G.; Gochev, V.; Girova, T.; Stoyanova, A.; Geissler, M. Antifungal Activity of Eugenol and Various Eugenol-Containing Essential Oils against 38 Clinical Isolates of Candida albicans. J. Essent. Oil-Bear. Plants. 2007, 10, 421–429. [Google Scholar] [CrossRef]
- Schlösser, I.; Prange, A. Antifungal activity of selected natural preservatives against the foodborne molds Penicillium verrucosum and Aspergillus westerdijkiae. FEMS Microbiol. Lett. 2018, 365, 2018. [Google Scholar] [CrossRef] [PubMed]
- Burt, S. Essential oils: Their antibacterial properties and potential applications in foods—A review. Int. J. Food Microbiol. 2004, 94, 223–253. [Google Scholar] [CrossRef]
- Markovic, T.; Chatzopoulou, P.; Šiljegović, J.; Nikolić, M.; Glamočlija, J.; Ćirić, A.; Soković, M. Chemical analysis and antimicrobial activities of the essential oils of Satureja thymbra L. and Thymbra spicata L. and their main components. Arch. Biol. Sci. 2011, 63, 457–464. [Google Scholar] [CrossRef]
- Dammak, I.; Hamdi, Z.; El Euch, S.K.; Zemni, H.; Mliki, A.; Hassouna, M.; Lasram, S. Evaluation of antifungal and anti-ochratoxigenic activities of Salvia officinalis, Lavandula dentata and Laurus nobilis essential oils and a major monoterpene constituent 1,8-cineole against Aspergillus carbonarius. Ind. Crops Prod. 2019, 128, 85–93. [Google Scholar] [CrossRef]
- Santos, F.A.; Rao, V.S.N. Antiinflammatory and antinociceptive effects of 1,8-cineole a terpenoid oxide present in many plant essential oils. Phytother. Res. 2000, 14, 240–244. [Google Scholar] [CrossRef]
- Ochoa-Velasco, C.E.; Navarro-Cruz, A.R.; Vera-López, O.; Palou, E.; Avila-Sosa, R. Growth modeling to control (in vitro) Fusarium verticillioides and Rhizopus stolonifer with thymol and carvacrol. Rev. Argent. Microbiol. 2016, 50, 70–74. [Google Scholar] [CrossRef]
- Soković, M.D.; Vukojević, J.; Marin, P.D.; Brkić, D.D.; Vajs, V.; van Griensven, L.J.L.D. Chemical Composition of Essential Oils of Thymus and Mentha Species and Their Antifungal Activities. Molecules 2009, 14, 238–249. [Google Scholar] [CrossRef]
- Ju, J.; Xie, Y.; Yu, H.; Guo, Y.; Cheng, Y.; Chen, Y.; Ji, L.; Yao, W. Synergistic properties of citral and eugenol for the inactivation of foodborne molds in vitro and on bread. LWT-Food Sci.Technol. 2020, 122, 109063. [Google Scholar] [CrossRef]
- Tresserra-Rimbau, A.; Lamuela-Raventos, R.M.; Moreno, J.J. Polyphenols, food and pharma. Current knowledge and directions for future research. Biochem. Pharmacol. 2018, 156, 186–195. [Google Scholar] [CrossRef] [PubMed]
- Hernandez Ochoa, L.R. Substitution de Solvants et Matières Actives de Synthèse par un Combiné «Solvant/Actif » d’Origine Végétale. Ph.D. Thesis, Autonomous University of Chihuahua, Mexico City, Mexico, 2005. [Google Scholar]
- Hyldgaard, M.; Mygind, T.; Meyer, R.L. Essential Oils in Food Preservation: Mode of Action, Synergies, and Interactions with Food Matrix Components. Front. Microbiol. 2012, 3, 12. [Google Scholar] [CrossRef] [PubMed]
- Langeveld, W.T.; Veldhuizen, E.J.A.; Burt, S.A. Synergy between essential oil components and antibiotics: A review. Crit. Rev. Microbiol. 2014, 40, 76–94. [Google Scholar] [CrossRef] [PubMed]
- Ong, K.S.; Mawang, C.I.; Daniel-Jambun, D.; Lim, Y.Y.; Lee, S.M. Current anti-biofilm strategies and potential of antioxidants in biofilm control. Expert Rev. Anti-Infect. Ther. 2018, 16, 855–864. [Google Scholar] [CrossRef]
- Rhimi, W.; Theelen, B.; Boekhout, T.; Otranto, D.; Cafarchia, C. Malassezia spp. Yeasts of Emerging Concern in Fungemia. Front. Cell. Infect. Microbiol. 2020, 10, 370. [Google Scholar] [CrossRef]
- Guenther, E. The Essential Oils; D. Van Nostrand Company, Inc.: New York, NY, USA, 1948; Volume 1, pp. 339–340. [Google Scholar]
- Hmamou, A.; Eloutassi, N.; Alshawwa, S.Z.; Al kamaly, O.; Kara, M.; Bendaoud, A.; El-Assri, E.; Tlemcani, S.; El Khomsi, M.; Lahkimi, A. Total Phenolic Content and Antioxidant and Antimicrobial Activities of Papaver rhoeas L. Organ Extracts Growing in Taounate Region, Morocco. Molecules 2022, 27, 854. [Google Scholar] [CrossRef]
- Re, R.; Pellegrini, N.; Proteggente, A.; Pannala, A.; Yang, M.; Rice-Evans, C. Antioxidant activity applying an improved ABTS radical cation decolorization assay. Free Radic. Biol. Med. 1999, 26, 1231–1237. [Google Scholar] [CrossRef]
- Chebbac, K.; Ghneim, H.K.; El Moussaoui, A.; Bourhia, M.; El Barnossi, A.; Benziane Ouaritini, Z.; Salamatullah, A.M.; Alzahrani, A.; Aboul-Soud, M.A.M.; Giesy, J.P.; et al. Antioxidant and Antimicrobial Activities of Chemically-Characterized Essential Oil from Artemisia aragonensis Lam. against Drug-Resistant Microbes. Molecules 2022, 27, 1136. [Google Scholar] [CrossRef]
- Ngombo-Nzokwani, A.; Manyi, M.M.; Mbuyi, A.K.; Kanyenga, A.L. Identification des champignons transmis par les semences biofortifiées au Kongo Central en République Démocratique du Congo. Afr. Sci. 2017, 13, 1–11. [Google Scholar]
- Tsedaley, B. Detection and identification of major storage fungal pathogens of maize (zea mays L.) in jimma, southwestern ethiopia. Eur. J. For. Res. 2016, 4, 38–49. [Google Scholar]
- Nyongesa, B.W.; Okoth, S.; Ayugi, V. Identification Key for Aspergillus Species Isolated from Maize and Soil of Nandi County, Kenya. J. Adv. Microbiol. 2015, 5, 205–229. [Google Scholar] [CrossRef]
- Sawadogo, I.; Paré, A.; Kaboré, D.; Montet, D.; Durand, N.; Bouajila, J.; Zida, E.P.; Sawadogo-Lingani, H.; Nikiéma, P.A.; Charles Nebié, R.H.; et al. Antifungal and Antiaflatoxinogenic Effects of Cymbopogon citratus, Cymbopogon nardus, and Cymbopogon schoenanthus Essential Oils Alone and in Combination. J. Fungi. 2022, 8, 117. [Google Scholar] [CrossRef] [PubMed]

| Essential Oils | Extraction Yield (%) |
|---|---|
| Rosmarinus officinalis | 2.52 |
| Origanum compactum | 1.6 |
| Eugenia aromatica | 15 |
| Myrtus communis | 0.4 |
| Essential Oils | Compounds | Molecular Formula | Composition (%) |
|---|---|---|---|
| Rosmarinus officinalis | α-Pinene | C10H16 | 2.45 a |
| Camphene | C10H16 | 3.77 c | |
| β-Myrcene | C10H16 | 2.80 b | |
| 1,8-Cineole | C10H18O | 48.22 f | |
| Camphor | C10H16O | 22.58 e | |
| α-Terpineol | C10H18O | 4.36 d | |
| Myrtus communis | α-Pinene | C10H16 | 17.56 f |
| 1,8-Cineole | C10H18O | 42.22 g | |
| Linalool | C10H18O | 2.80 b | |
| α-Terpineol | C10H18O | 3.31 c | |
| Myrtenol | C10H16O | 3.32 d | |
| Myrtenyl acetate | C12H18O2 | 15.06 e | |
| Geranyl acetate | C12H20O2 | 1.92 a | |
| Eugenia aromatica | Eugenol | C10H12O2 | 96.29 d |
| Eugenyl acetate | C12H14O3 | 0.72 b | |
| α-Humulene | C15H24 | 0.54 a | |
| Caryophyllene | C15H24 | 2.02 c | |
| Origanum compactum | α-Thujene | C10H16 | 2.26 c |
| Myrcene | C10H16 | 4.85 e | |
| p-Cymene | C10H14 | 3.91 d | |
| γ-Terpinene | C10H16 | 0.33 a | |
| Carvacrol | C10H14O | 79.20 f | |
| Caryophyllene | C15H24 | 1.55 b |
| Essential Oils | Reducing Capacity TAC (mgAE/gEO) | Scavenging Capacity | |
|---|---|---|---|
| DPPH IC50 (mg/mL) | ABTS IC50 (mg/mL) | ||
| R. officinalis O. compactum E. aromatica M. communis | 199.952 ± 7.393 b 154.238 ± 12.957 a 748.365 ± 3.016 c 200.429 ± 3.898 b | 91.117 ± 3.180 b 3.937 ± 0.111 a 0.006 ± 0.001 a 91.312 ±1.146 b | 48.940 ± 2.484 b 1.813 ± 0.042 a 0.0241 ± 0.0001 a 98.501 ± 1.105 c |
| Ascorbic acid | - | 0.037 ± 0.003 a | 0.132 ± 0.000 a |
| Essential Oils | F. culmorum | R. oryzae | P. italicum | A. niger | |
|---|---|---|---|---|---|
| R. officinalis | MIC (µL/mL) MFC (µL/mL) MFC/MIC Interpretation | 6.25 c 6.25 b 1.00 Fungicide | 6.25 d 25.00 c 4.00 Fungicide | 8.33 ± 2.08 b 25.00 c 3.00 Fungicide | 12.50 c 50.00 c 4.00 Fungicide |
| O. compactum | MIC (µL/mL) MFC (µL/mL) MFC/MIC Interpretation | 0.781 b 1.302 ± 0.260 a 1.67 Fungicide | 3.125 c 6.25 b 2.00 Fungicide | 0.781 a 3.125 b 4.00 Fungicide | 1.562 b 3.125 b 2.00 Fungicide |
| E. aromatica | MIC (µL/mL) MFC (µL/mL) MFC/MIC Interpretation MIC (µL/mL) MFC (µL/mL) MFC/MIC Interpretation | 0.13 ± 0.03 a 0.651 ± 0.130 a 4.99 Fungistatic 12.50 d 25.00 c 2.00 Fungicide | 0.098 a 0.781 a 7.97 Fungistatic 25.00 e 50.00 d 2.00 Fungicide | 0.13 ± 0.03 a 1.562 a 11.98 Fungistatic 12.50 b 50.00 d 4.00 Fungicide | 0.098 a 0.781 a 7.97 Fungistatic 12.50 c 50.00 c 4.00 Fungicide |
| M. communis | |||||
| Azoxystrobin | MIC (µL/mL) | 1.302 ± 0.451 b | 0.520 ± 0.226 b | 0.651 ± 0.226 a | 0.098 a |
| Main Components | F. culmorum | R. oryzae | P. italicum | A. niger | |
|---|---|---|---|---|---|
| 1,8-Cineole | MIC (µL/mL) MFC (µL/mL) MFC/MIC Interpretation | 12.50 c 25.00 c 2.00 Fungicide | 10.437 c 41.75 c 4.00 Fungicide | 17.39 ± 3.47 b 83.5 c 4.00 Fungicide | 41.75 c 167.00 c 4.00 Fungicide |
| Carvacrol | MIC (µL/mL) MFC (µL/mL) MFC/MIC Interpretation | 0.098 a 0.195 a 1.99 Fungicide | 0.098 a 0.195 a 1.99 Fungicide | 0.13 ± 0.03 a 0.39 a 3.00 Fungicide | 0.098 a 0.195 a 1.99 Fungicide |
| Eugenol | MIC (µL/mL) MFC (µL/mL) MFC/MIC Interpretation | 0.39 b 0.781 b 2.00 Fungicide | 0.39 b 1.562 b 4.01 Fungicide | 0.195 a 0.781 b 4.01 Fungicide | 0.781 b 1.562 b 2.00 Fungicide |
| Mixtures | F. culmorum | R. oryzae | P. italicum | A. niger | |
|---|---|---|---|---|---|
| Mix. 1 | MIC (µL/mL) MFC (µL/mL) | 0.260 ± 0.113 a,b 0.39 a | 0.195 b 0.781 b | 0.163 ± 0.056 a,b 0.651 ± 0.226 a | 0.260 ± 0.113 a,b 0.39 a |
| Mix. 2 | MIC (µL/mL) MFC (µL/mL) | 0.098 a 0.39 a | 0.098 a 0.39 a | 0.098 a 0.651 ± 0.226 a | 0.098 a 0.325 ± 0.113 a |
| Mix. 3 | MIC (µL/mL) MFC (µL/mL) | 0.39 b 0.39 a | 0.39 c 0.781 b | 0.195 b 1.562 b | 0.39 b 0.781 b |
| Mixtures | F. culmorum | R. oryzae | P. italicum | A. niger | |
|---|---|---|---|---|---|
| Carvacrol (µL/mL) | MIC | 0.098 | 0.098 | 0.13 ± 0.03 | 0.098 |
| Eugenol (µL/mL) | MIC | 0.39 | 0.39 | 0.195 | 0.781 |
| Mix. 1 | MIC of Mix 1 FIC of CAR FIC of EUG FICI | 0.260 ± 0.113 1.33 0.33 1.66 Indifferent | 0.195 0.99 0.25 1.24 Indifferent | 0.163 ± 0.056 0.62 0.42 1.04 Indifferent | 0.260 ± 0.113 1.33 0.17 1.49 Indifferent |
| Mix. 2 | MIC of Mix 2 FIC of CAR FIC of EUG FICI Interpretation | 0.098 0.75 0.06 0.81 Additive | 0.098 0.75 0.06 0.81 Additive | 0.098 0.57 0.13 0.69 Additive | 0.098 0.75 0.03 0.78 Additive |
| Mix. 3 | MIC of Mix 3 FIC of CAR FIC of EUG FICI Interpretation | 0.39 0.99 0.75 1.74 Indifferent | 0.39 0.99 0.75 1.74 Indifferent | 0.195 0.38 0.75 1.13 Indifferent | 0.39 0.99 0.37 1.37 Indifferent |
| Species Name | Family | Parts Used | Harvesting Location | Harvesting Season |
|---|---|---|---|---|
| Rosmarinus officinalis | Lamiaceae | Leaves + small stems | Midelt region | June–September |
| Origanum compactum | Lamiaceae | Leaves + small stems | Ouazzane region | June–August |
| Myrtus communis | Myrtaceae | Leaves | Marrakech region | May–June |
| Eugenia aromatica | Myrtaceae | Flowers | Herbalist | - |
| Mixture | Eugenol | Carvacrol |
|---|---|---|
| Mix. 1 | 1 | 1 |
| Mix. 2 | 1 | 3 |
| Mix. 3 | 3 | 1 |
Disclaimer/Publisher’s Note: The statements, opinions and data contained in all publications are solely those of the individual author(s) and contributor(s) and not of MDPI and/or the editor(s). MDPI and/or the editor(s) disclaim responsibility for any injury to people or property resulting from any ideas, methods, instructions or products referred to in the content. |
© 2023 by the authors. Licensee MDPI, Basel, Switzerland. This article is an open access article distributed under the terms and conditions of the Creative Commons Attribution (CC BY) license (https://creativecommons.org/licenses/by/4.0/).
Share and Cite
Et-tazy, L.; Lamiri, A.; Satia, L.; Essahli, M.; Krimi Bencheqroun, S. In Vitro Antioxidant and Antifungal Activities of Four Essential Oils and Their Major Compounds against Post-Harvest Fungi Associated with Chickpea in Storage. Plants 2023, 12, 3587. https://doi.org/10.3390/plants12203587
Et-tazy L, Lamiri A, Satia L, Essahli M, Krimi Bencheqroun S. In Vitro Antioxidant and Antifungal Activities of Four Essential Oils and Their Major Compounds against Post-Harvest Fungi Associated with Chickpea in Storage. Plants. 2023; 12(20):3587. https://doi.org/10.3390/plants12203587
Chicago/Turabian StyleEt-tazy, Lamyae, Abdeslam Lamiri, Laila Satia, Mohamed Essahli, and Sanae Krimi Bencheqroun. 2023. "In Vitro Antioxidant and Antifungal Activities of Four Essential Oils and Their Major Compounds against Post-Harvest Fungi Associated with Chickpea in Storage" Plants 12, no. 20: 3587. https://doi.org/10.3390/plants12203587
APA StyleEt-tazy, L., Lamiri, A., Satia, L., Essahli, M., & Krimi Bencheqroun, S. (2023). In Vitro Antioxidant and Antifungal Activities of Four Essential Oils and Their Major Compounds against Post-Harvest Fungi Associated with Chickpea in Storage. Plants, 12(20), 3587. https://doi.org/10.3390/plants12203587






